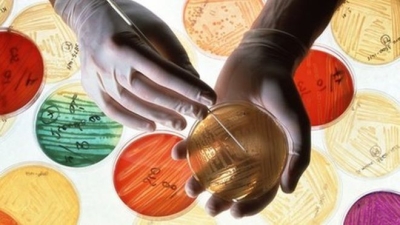
¿Por qué es importante no tomar antibióticos autorecetados?

Medicina Digital
Diario Médico de México
Medicina Digital
Diario Médico de México
# Entérese
- Botones de vida, solución clave para la seguridad en el autismo
- Papel clave del baño en el bienestar cotidiano
- La IA revela el alcance oculto del marketing de refrescos y alcohol en las redes sociales, estudio
- ARTÍCULO :: Análisis bioético y metafísico del “aborto después de nacer”…
- Con 42 años impulsando la ciencia hecha en México, Roche abre la convocatoria del Premio Rosenkranz 2026
- La Industria Farmacéutica y de Dispositivos Médicos eje estratégico para Plan México
- Reconocer, tratar y prevenir las lesiones más comunes en deportistas
- Llega a México innovadora tecnología para tratar crisis epilépticas
Medicamentos (293)
Nuevo tratamiento para espondiloartritis podría beneficiar alrededor de 96 mil mexicanos
Ciudad de México. Durante la quincuagésima segunda edición del Congreso Mexicano de Reumatología, que se llevó a cabo en la ciudad de Monterrey, la biofarmacéutica AbbVie reafirmó su compromiso con el avance de la ciencia presentando una terapia oral como una alternativa innovadora para mejorar la atención médica de las personas que viven con Espondilitis Anquilosante (EA) y Artritis Psoriásica (APs), con lo cual, la compañía continua transformando los estándares de atención a través de la innovación científica.
La vacuna actualizada contra COVID-19 de Moderna ya está disponible en las farmacias de México
Ciudad de México. Con el compromiso compartido de proteger la salud de la población mexicana, Asofarma trabaja de la mano con las autoridades sanitarias y el sector privado para que la vacuna Moderna COVID-19 esté disponible a partir del martes 16 de enero de 2024, garantizando estrategias que aseguren una disponibilidad integral y eficiente.
Ciudad de México. La forma adecuada de utilizar los antibióticos es un pilar fundamental en la salud global, su importancia radica en el impacto directo en la calidad de vida de las personas y en la sostenibilidad de los sistemas de salud. Por ello, desde el próximo 18 al 24 de noviembre se celebra la Semana Mundial de Concientización sobre el Uso de los Antibióticos, iniciativa que pretende aumentar la conciencia mundial en torno a la resistencia a los antibióticos y estimular mejores prácticas para garantizar tratamientos efectivos y un mejor control de las infecciones a largo plazo.
Ciudad de México. En México cada año se diagnostican 29 mil 929 nuevos casos de cáncer de mama, de los cuales 7 mil 931[2] se reflejan en muertes. Ante este panorama desde hace más de 30 años en Roche nos hemos comprometido a investigar y desarrollar nuevas y mejores terapias para cambiar el tratamiento de esta enfermedad, trayendo a las pacientes, especialistas y sistemas de salud, alternativas para enfrentar el desafío médico que el cáncer de mama representa para las mujeres mexicanas y para el sistema de salud.
Ciudad de México. En México cada año se diagnostican 29 mil 929 nuevos casos de cáncer de mama, de los cuales 7 mil 931[2] se reflejan en muertes. Ante este panorama desde hace más de 30 años en Roche nos hemos comprometido a investigar y desarrollar nuevas y mejores terapias para cambiar el tratamiento de esta enfermedad, trayendo a las pacientes, especialistas y sistemas de salud, alternativas para enfrentar el desafío médico que el cáncer de mama representa para las mujeres mexicanas y para el sistema de salud.
Ciudad de México. Los medicamentos desarrollados en los últimos años para tratar las migrañas están mejorando significativamente la calidad de vida de quienes padecen esta afección debilitante, según un experto del sistema mundial de salud mundial Cleveland Clinic.
México. Nueva terapia aprobada para mutaciones específicas promete una atención más personalizada
Ciudad de México. Recientemente, la Comisión Federal para la Protección contra Riesgos Sanitarios (COFEPRIS) aprobó la terapia Amivantamab para el tratamiento de pacientes adultos con cáncer de pulmón de células no pequeñas (CPCNP) avanzado o metastásico con mutaciones genéticas. Este nuevo fármaco permitirá brindar atención especializada a pacientes con necesidades muy específicas para el tratamiento de este tipo de cáncer.
Ver notas por categoría
Lo + visto
Jul 05 2020 232784
Gasdem B, suplemento alimenticio creado con nanotecnología mexicana
Anuncio en blogs de categorías